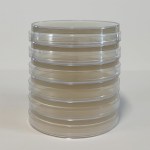
51ZXXJzVyML._SL1024_

Manufacturer:
Andex Biotech
Results 1 - 9 of 9
Laboratory supplies
Peptone Powder, Bacteriological Grade, 60g
Peptone Powder, Bacteriological Grade
Sales price: £19.99
Malt Extract Powder, Bacteriological Grade, 60g
Malt Extract Powder, Bacteriological Grade
Sales price: £17.99
Yeast Extract Powder, Bacteriological Grade (60 g)
Yeast Extract Powder, Bacteriological Grade (60 g)
Sales price: £16.99
Pack of 40 sterile Petri dishes (90mm x 15mm) with lids and Parafilm
Pack of 40 sterile Petri dishes (90mm x 15mm) with lids and ...
Sales price: £16.99
Malt Extract Yeast Agar (MEYA) Powder to Grow Microorganisms, Bacteriological grade, in a Bottle (36 g)
Malt Extract Yeast Agar (MEYA) Powder to Grow ...
Sales price: £13.99
Potato Dextrose Agar (PDA) Pre-poured Petri Dishes (6)
Potato Dextrose Agar (PDA) Pre-poured Petri Dishes (6)
Sales price: £9.00
Pre-poured MEYA (Malt Extract Yeast Agar) Agar Petri Dishes in 90mm Plates 10pcs
Pre-poured MEYA (Malt Extract Yeast Agar) Agar Petri ...
Sales price: £17.99
Bacteria Science Kit Petri Dishes with Agar Educational STEM Science Fair Project Kit
Bacteria Science Kit Petri Dishes with Agar Educational ...
Sales price: £19.99